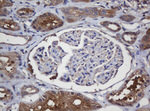
CRYAA Antibody in Immunohistochemistry (Paraffin) (IHC (P))
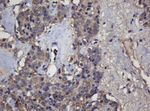
CRYAA Antibody in Immunohistochemistry (Paraffin) (IHC (P))

Search
OriGene
CRYAA Monoclonal Antibody (OTI2C3), TrueMAB™
{{$productOrderCtrl.translations['antibody.pdp.commerceCard.promotion.promotions']}}
{{$productOrderCtrl.translations['antibody.pdp.commerceCard.promotion.viewpromo']}}
{{$productOrderCtrl.translations['antibody.pdp.commerceCard.promotion.promocode']}}: {{promo.promoCode}} {{promo.promoTitle}} {{promo.promoDescription}}. {{$productOrderCtrl.translations['antibody.pdp.commerceCard.promotion.learnmore']}}

Please note: We are reviewing Western blot images included in the antibody testing data in our catalog, including those provided by third parties. Unless expressly labeled or annotated as “raw-unedited”, Western blot images included in the antibody testing data in our catalog may have been edited, optimized or otherwise adjusted for presentation.
产品信息
CF505453
宿主/亚型
分类
类型
克隆号
抗原
偶联物
形式
浓度
规格
保存条件
运输条件
产品详细信息
For reconstitution, we recommend adding 100 µL distilled water to a final antibody concentration of about 1 mg/mL. To use this carrier-free antibody for conjugation experiments, we strongly recommend performing another round of desalting. (Zeba Spin Desalting Columns, 7KMWCO, 0.5 mL, Product # 89882)
靶标信息
Lens proteins consist almost entirely of crystallins (about 95%). Crystallins are also found vertebrate skeletal muscle tissue. In the lens, their structural function is to assist in maintaining the proper refractive index of the lens. The mammalian lens contains 3 major classes of crystallins: alpha, beta, and gamma. Alpha-crystallin is the largest of the crystallins and is composed of 2 primary gene products-alpha-A and alpha-B. There are at least 5 different proteins comprising the beta-crystallins. The gamma-crystallins are monomeric, but there are at least 5 gamma crystallins identified in bovine and rat lens. Alpha-Crystallin comprises 40% of total lens protein composition. In addition to maintaining proper refractive index, it also functions in a chaperone like manner by preventing the formation of aggregates possibly leading to cataract formation. It is believed that the phosphorylated states of the alpha-crystallin occur in response to cellular stress and may serve a structural control function and play a role in protein maintenance. Alpha-B crystallin has been linked to Alexander's disease where it accumulates in brain cells of those afflicted.
仅用于科研。不用于诊断过程。未经明确授权不得转售。




